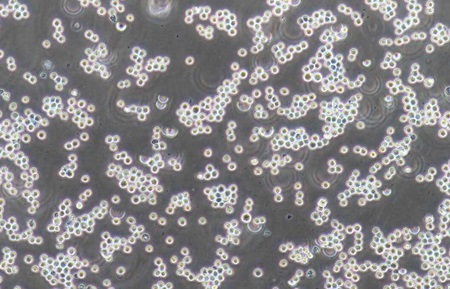
人慢性骨髓性白血病细胞系K562 人慢性骨髓性白血病细胞系K562

人慢性骨髓性白血病细胞系K562
|
|
|
- CAS号:
- 英文名:
- Human chronic myelogenous leukemia cell line K562
- 英文别名:
- 中文名:
- 人慢性骨髓性白血病细胞系K562
- 中文别名:
- 人慢性骨髓性白血病细胞系K562
- CBNumber:
- CB76205082
- 分子式:
- 分子量:
- 0
- MOL File:
- Mol file
|
|
|
人慢性骨髓性白血病细胞系K562性质、用途与生产工艺
人慢性骨髓性白血病细胞系K562是一种源自人慢性髓系白血病(CML)患者的骨髓样本的永生化细胞系。它最初由Lozzio等人在1970年从一位53岁女性患者的胸水中分离建立。
人慢性骨髓性白血病细胞系K562具有典型的费城染色体(Philadelphia chromosome),这是CML的标志性特征,由9号和22号染色体的易位形成,导致BCR/ABL1融合基因的产生。
淋巴母细胞样
悬浮生长
在裸鼠中具有致瘤性,皮下接种10^7个细胞后21天内以100%的频率发展成肿瘤。
人慢性骨髓性白血病细胞系K562
上下游产品信息
上游原料
下游产品